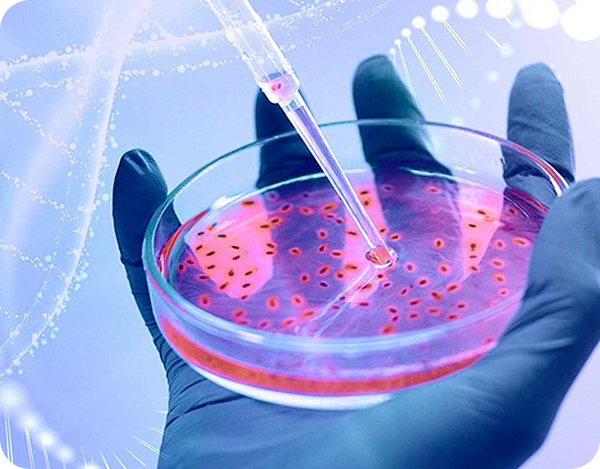
染色质免疫沉淀（ChIP）

- 首页
- 产品
-
信号通路
- 细胞进程相关信号通路(Cellular Processes)
- 细胞的环境信息应答相关信号通路(Environmental Information Processing)
- 人类疾病相关信号通路(Human Diseases)
-
机体系统相关通路研究(Organismal Systems)
- 免疫相关通路(Immune-Related Pathways)
- 造血与凝血相关通路(Hematopoietic & Coagulation-Related Pathways)
- 内分泌与代谢相关通路(Endocrine & Metabolic Pathways)
- 神经相关通路(Neural-Related Pathways)
- 心血管与肌肉相关通路(Cardiovascular & Muscle-Related Pathways)
- 发育与衰老相关通路(Development & Aging-Related Pathways)
- 节律与信号调控相关通路(Rhythm & Signal Regulation Pathways)
- 遗传信息调控相关信号通路(Genetic Information Processing)
- 支持中心
- 联系我们

实验常见问题解析
聚焦生命科学研究中核心实验技术的常见问题,我们针对实验流程、结果异常、操作难点等关键痛点提供专业解析与解决方案,助力科研人员高效排查实验问题、优化实验方案。